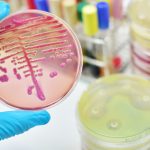

Aveva denunciato la presenza di sostanze cancerogene nell’acqua bevuta su una nave della Marina. Oggi si ritrova rinviato a giudizio.
Troupe fermata e materiale sequestrato. È la sorte toccata a una “spedizione” de Le Iene, capitana dal giornalista Luigi Pelazza, all’interno dell’arsenale di La Spezia, mentre girava un servizio relativo all’inchiesta sull’acqua contaminata sulle navi della Marina militare.
La troupe è stata sottoposta a perquisizione personale e veicolare. Sono stati sequestrati i video girati e una mini telecamera. «Siamo entrati senza che nessuno ci fermasse e non c’erano cartelli con la scritta “Alt” – ha dichiarato Pelazza –. Dopo circa dieci minuti, ci hanno fermato per accertamenti, bloccandoci con un mezzo posto di traverso all’uscita. Adesso ci sequestrano il materiale e dicono che non ci possono fare una copia».
La vicenda
Nel 2011 il maresciallo infermiere Emiliano Boi, in servizio a La Spezia, si accorgeva che l’acqua bevuta sulla nave Caio Duilio, autoprodotta con dei dissalatori, non era conforme all’uso umano, ma era usata anche per cucinare. Le analisi mostravano la presenza di trialometani e idrocarburi, sostanze cancerogene. Il maresciallo Boi, però, veniva sospeso e oggi si ritrova rinviato a giudizio con l’accusa di aver trasmesso un messaggio riservato, rivelando il contenuto degli accertamenti condotti sulla potabilità dell’acqua.
I servizi de Le Iene
Luigi Pelazza si è interessato alla vicenda realizzando un servizio nei mesi scorsi. Ieri mattina, a bordo di un gommone, ha cercato di raggiungere la nave Magnaghi per avvertire il comandante che i 58 uomini dell’equipaggio rischiano di bere acqua non idonea al consumo umano. Nel pomeriggio è arrivato il fermo all’interno dell’arsenale. «Non ci fermeremo – ha annunciato la Iena –. Chiederemo il dissequestro dei video».
Fonte: www.corriere.it

Lascia un commento